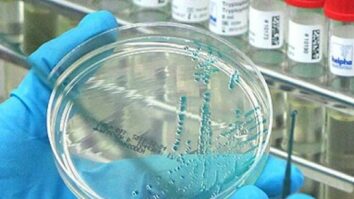

23 Haziran 2026 Salı, 22:14 Şu anda hava ![]() Son Dakika
Son Dakika
Bursa’da Nâzım’ı yazma serüvenlerini anlattılar
Şehir peyzajcılarına standart geliyor… 81 ilin bitki rehberi hazırlanıyor
Şam Havalimanı yenileniyor… İki adet yerli üretim ARFF aracı Suriye’ye gönderildi
İstanbul Büyükşehir ‘Ebeveyn Okulu’ açtı
Araç kiralamada kârsız yıl geçti!
Tom ve Jerry 85 yaşında
2025 Buyaz Öykü Onur Ödülü Nazmi Bayrı’nın
Bursa Mudanya Kapalı Yüzme Havuzu açıldı
Bursa’da sevimli can dostlar yeni yuvalarına kavuştu
Bursa Yıldırım’da Karadeniz rüzgarı
Yılın ilk ayı 112 bin 173 konut satıldı… İstanbul ve Rusya konut satışlarında liderliklerini korudu
OECD’de Bakan Göktaş’tan ‘Aile’ vurgusu